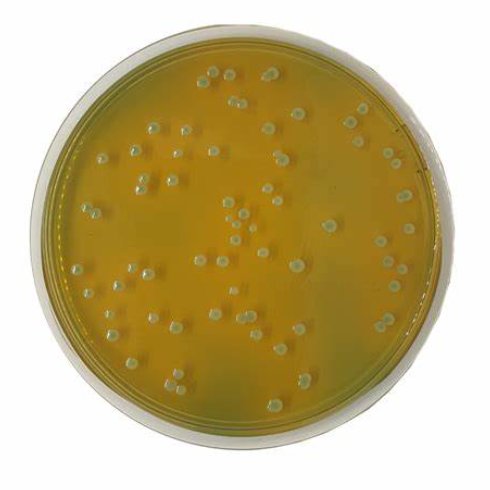
agar是什么意思

agar是什么意思
的有关信息介绍如下:agar意为:琼脂(一种植物胶);(Agar)人名;(英)阿加;(西、土)阿加尔

agar短语:
1.agarmedium 琼脂培养基
2.agarplate 琼脂板
3.agargel 琼脂凝胶
agar相关例句:
Agariscomplexpolysaccharide,extractedfromredalgae.
琼脂是从红藻中提取的复合多糖。
Spirochetesandorganismsthatshowglidingmovementcanmoveoverorthroughanagargel.
螺旋体和具有滑翔运动的生物体可以在琼脂凝胶上或通过琼脂凝胶。
Thevirulentstrainshadapolysaccharidecapsuleandformedsmoothcoloniesonagarmedium.
毒株具有多糖囊,在琼脂培养基上形成光滑的菌落。



